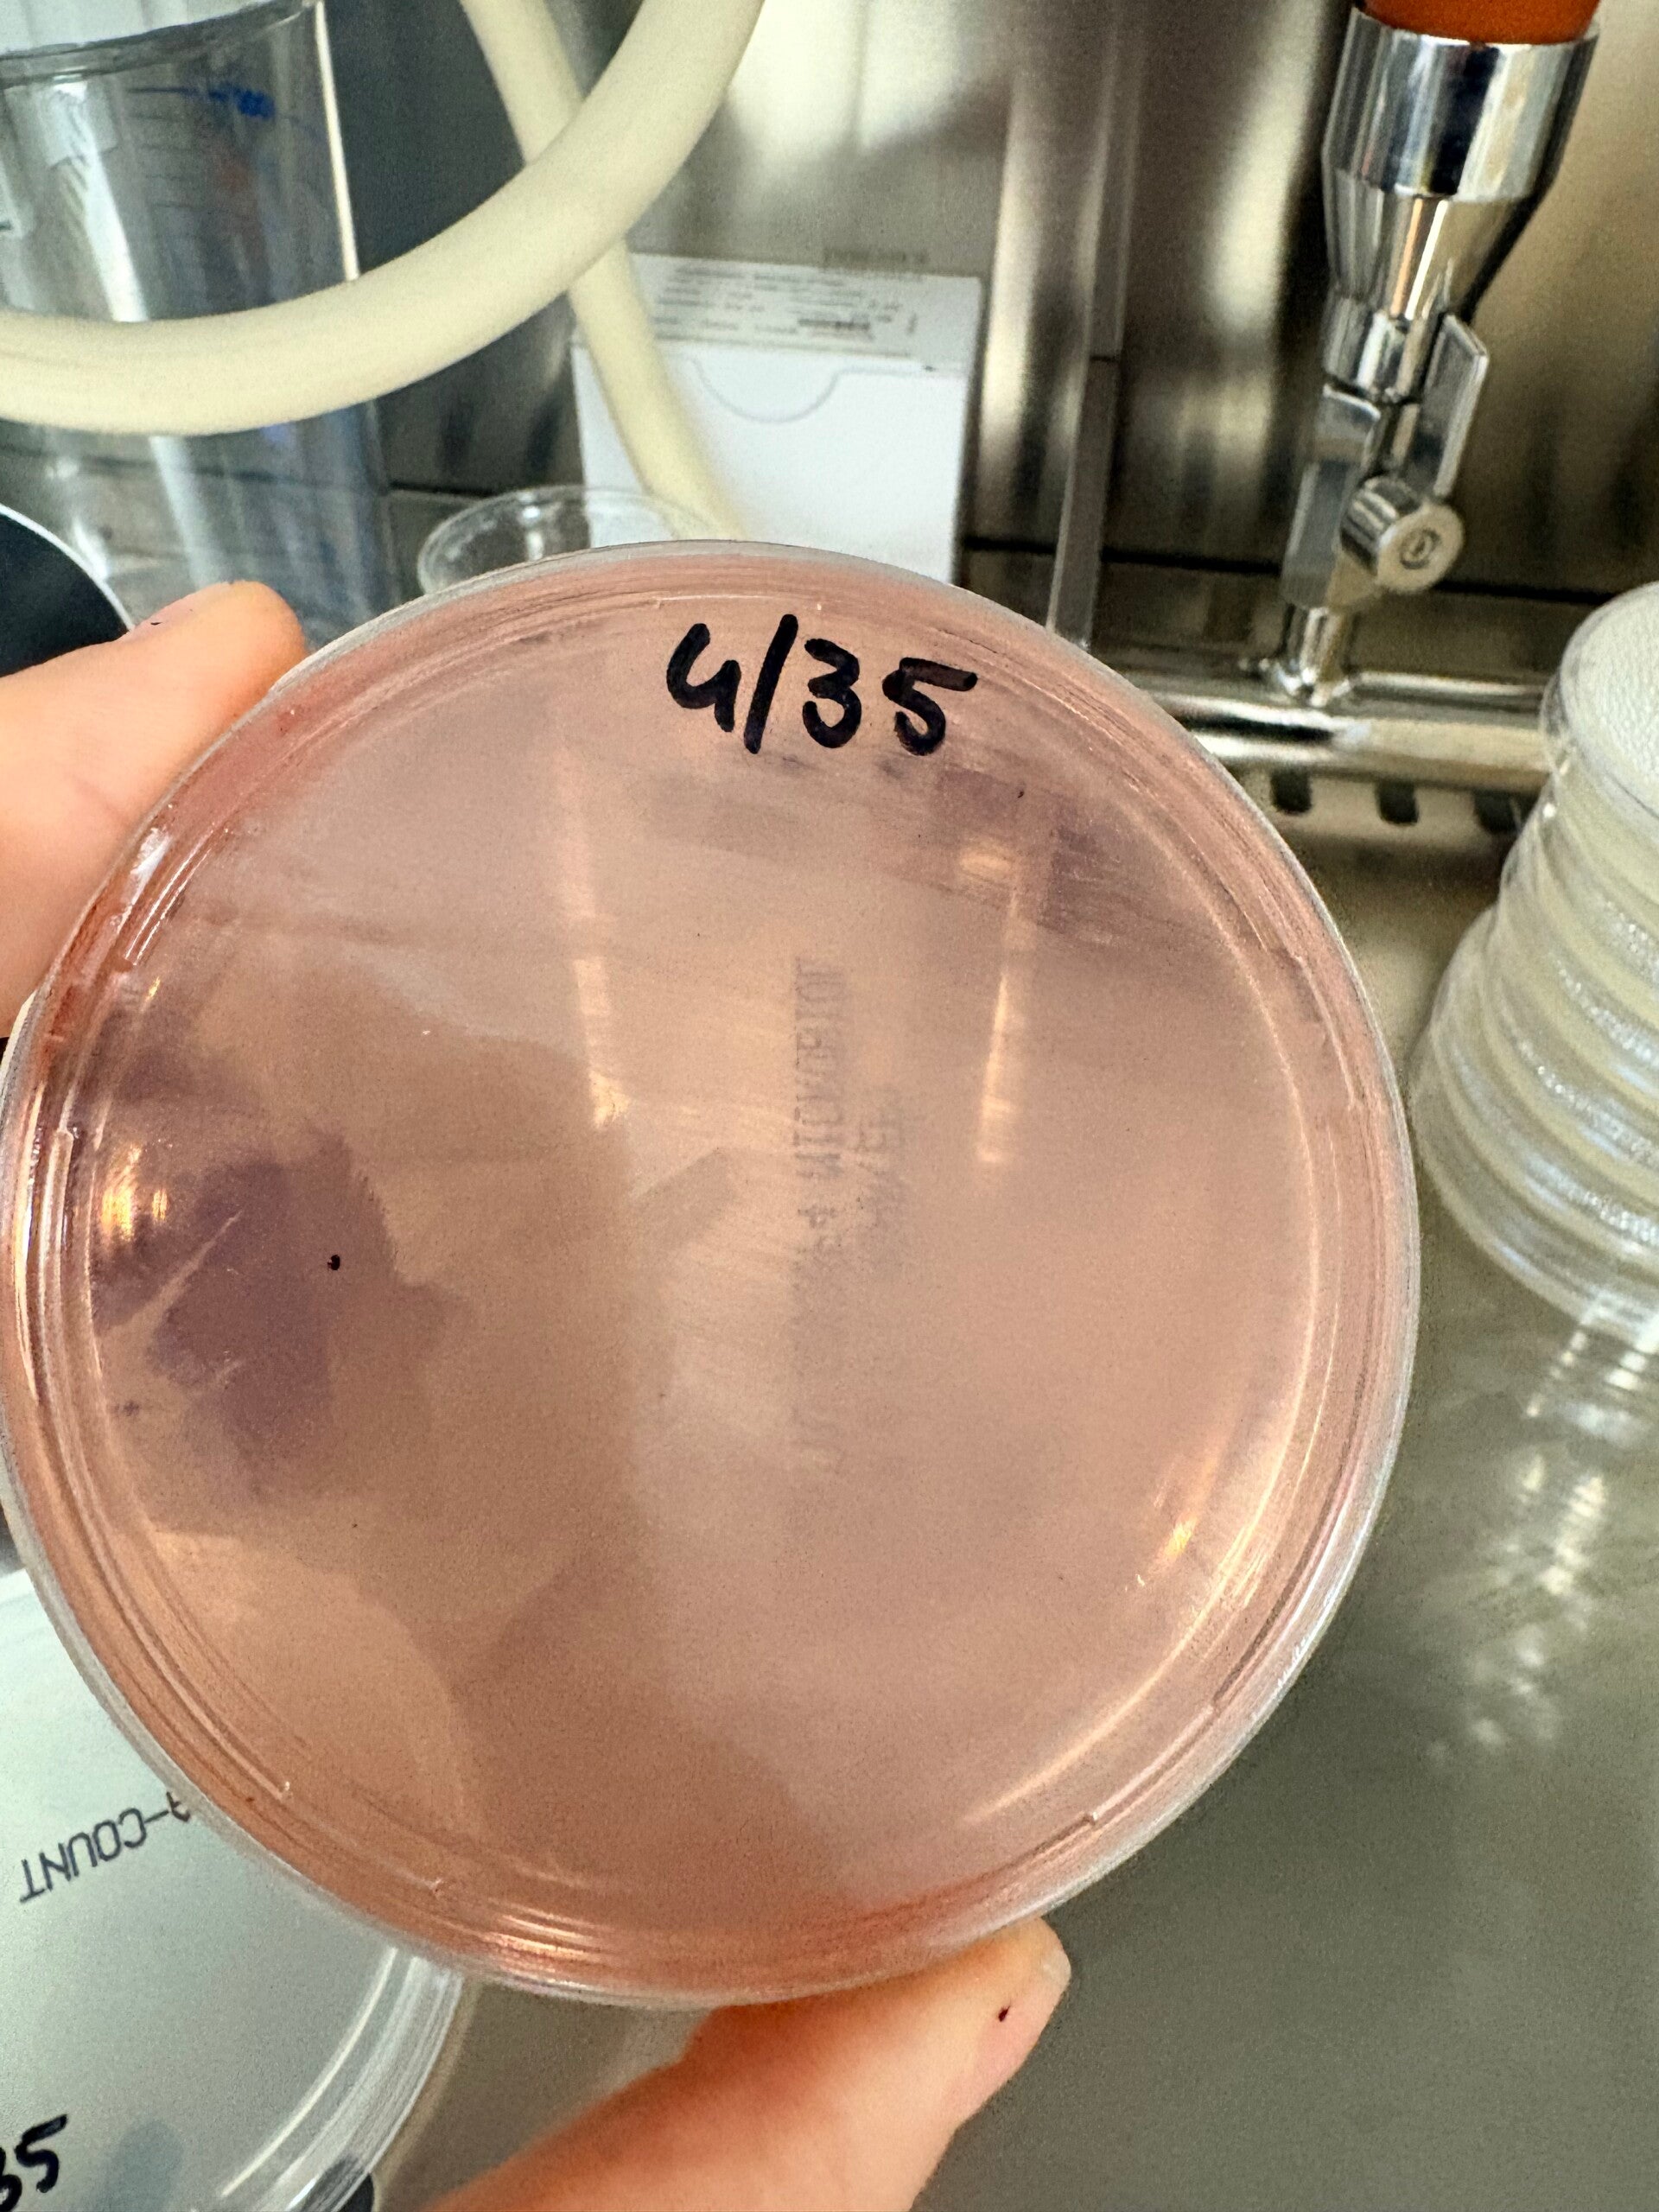

Le nostre certificazioni: garanzia di eccellenza
In un settore cruciale come quello agroalimentare, la trasparenza e l'aderenza alle normative sono fondamentali. Noi di Wineconsulting, azienda specializzata in consulenza microbiologica su vino e birra con sede a Milano, garantiamo ai nostri clienti servizi analitici conformi e affidabili. Scoprite le nostre certificazioni e il valore che portano al vostro business.

Iscritti negli elenchi regionali per analisi di autocontrollo haccp
Siamo orgogliosi di annunciare la nostra iscrizione negli elenchi regionali con riserva della Toscana per le analisi di autocontrollo HACCP. Questa è una certificazione chiave che attesta la nostra competenza e il nostro impegno verso gli standard più elevati, offrendo tranquillità a cantine, birrifici e a tutta la filiera agroalimentare.
con numero 085
La nostra promessa: legalità e fiducia
Il messaggio è chiaro e diretto: siamo iscritti, siamo legali, venite da noi. LV è la scelta affidabile per le vostre esigenze di consulenza microbiologica e analisi. Con noi, scegliete un partner che garantisce conformità, professionalità e un servizio ineccepibile, per la crescita e il successo della vostra attività nel settore agroalimentare.